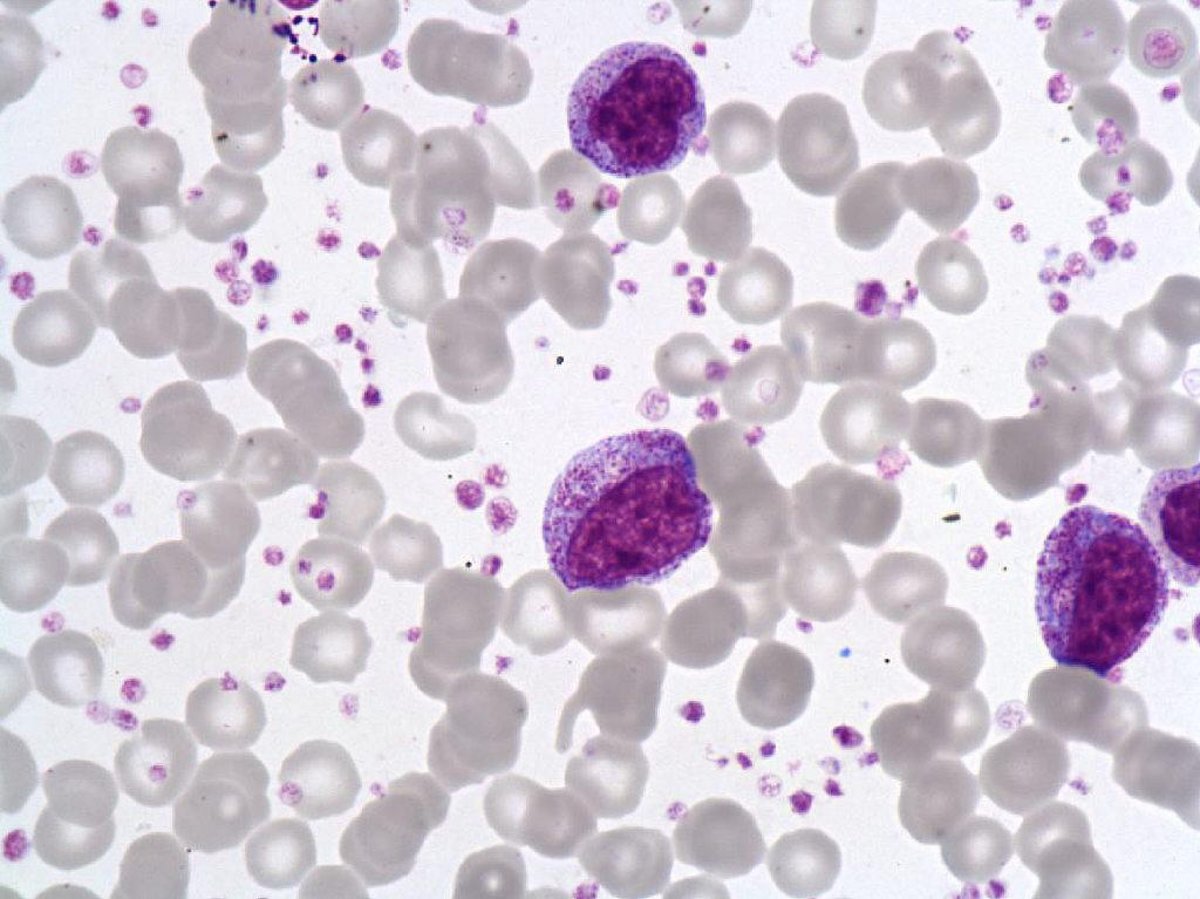
post img

Impact of D-dimer level on postinterventional coronary flow and in-hospital MACE in ST-segment elevation myocardial infarction
Methods and results: A total of 266 consecutive patients presenting with STEMI within the first 12 h of symptom onset were included in this study. Patients were divided into two groups based on the postinterventional Thrombolysis In Myocardial Infarction (TIMI) flow grade score. Postinterventional TIMI grades of 0, 1, or 2 were defined as no-reflow (group 1) and angiographic success was defined as TIMI 3 flow (group 2). D-dimer levels were significantly higher in patients with postinterventional no-reflow than in patients with postinterventional TIMI grade 3 flow (686 ± 236 μg/ml-418 ± 164 μg/ml, p < 0.001). Multivariate logistic regression analysis showed that D-dimer level was an independent predictor of postinterventional no-reflow (OR: 1.005; 95 % CI: 1.003-1.007; p < 0.001) and in-hospital major adverse cardiovascular events (MACE; OR: 1.002; 95 % CI: 1.000-1.004; p = 0.029). Receiver operator characteristics analysis provided a cut-off value of 549 μg/ml for D-dimer for predicting no-reflow with an 83 % sensitivity and an 81 % specificity, and 544 μg/ml for predicting in-hospital MACE with a 69 % sensitivity and a 67 % specificity.
Conclusion: In conclusion, D-dimer levels measured on admission may be an independent predictor of no-reflow, which is also a predictor of adverse outcomes in patients with STEMI.

0 yorum